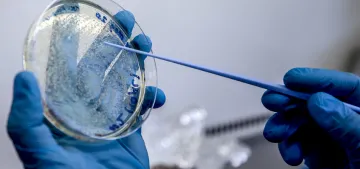
Hepatit virüsü taşıyan 10 kişiden 9'u bundan habersiz

Birçok yerde koronavirüs (Covid-19) salgınına karşı mücadele kapsamında maske takmak artık günlük hayatın bir parçası haline geldi. n-tv.de adlı haber sitesinin haberinde yer alan iş yerinde maske takma zorunluluğu hakkındaki soru ve cevaplar ile bu konuda bilinmesi gerekenleri okurlarımız için derledik.
İŞ YERİNDE MASKE TAKMAK ZORUNDA MIYIM?
Öncelikle her işverenin çalışanlarına karşı koruma ve kollama zorunluluğu vardır. Mevcut yasal düzenlemelere göre, işverenler tarafından korona salgını sırasında işyerinde yayılma riskinin olabildiğince düşük olması sağlanmalıdır. İş sağlığı ve güvenliği gereğince çalışanlar arasında 1,5 metrelik bir mesafenin korunması gerektiyor. Bu mesafe kuralına uyulamayan durumlarda, çalışanların karşılıklı önlem amacıyla maske takmaları gerekiyor. İş sağlığı ve güvenliği standartlarına uyan şirketler, yasal olarak güvenli bir şekilde hareket ettiklerini varsayabilirler. Ancak bazı durumlarda yerel olarak geçerli düzenlemeler bu iş güvenliği kuralının ötesine de geçebiliyor. Bu nedenle iş yeri ve yerel olarak geçerli düzenlemeler mutlaka dikkate alınmalıdır.
İŞ YERİNDE MASKE TAKMAYI REDDEDERSEM NE OLUR?
İşveren, yönlendirme veya yönerge (talimat) verme hakkına sahip olduğu için, iş yerinde koruyucu bir maske takılması talimatını verebilir. Bu uygulama işverenin hakkı kapsamındadır. Verdi Sendikası temsilcilerinin konu hakkında yaptığı açıklamaya göre işverenin böyle bir talimat vermeye yasal olarak hakkı olduğu için, çalışanların bu talimatı yerine getirmesi gerekmektedir. Bu talimata rağmen maske takmayı reddeden çalışanlar ilk etapta uyarı, bu ısrarlarının sürmesi halinde ise işten çıkarılma riskiyle karşı karşıya kalabilirler.
MASKE MASRAFLARINI HANGİ TARAF KARŞILAMALI?
İş hukuku uzmanı avukatların görüşlerine göre, bir işveren çalışanlarını iş yerinde salgının yayılmasından koruma amacıyla maske takma talimatı vermesi halinde, maske ve benzeri malzemeleri temin etmek ve ücretini ödemek durumundadır. Bu konuda esas olan konu ise, maskenin iş veya koruyucu giysi olarak sayılıp sayılmamasıyla ilgilidir. İşverenler iş kıyafetleri için yaptıkları masrafları vergiden düşebilseler de, normal şartlarda çalışanlar iş yerindeki giysilerini kendileri ödemek durumndadır. Ancak iş güvenlik ayakkabısı ve kask gibi iş güvenliğini sağlayan kıyafetler işveren tarafından ödenmelidir. Buradan hareketle salgının yayılmasını önlemek için iş yerinde maske takılması gerekiyorsa, maske temininin işveren tarafından yapılması gerekmektedir.
Haber: Emine Oran – (Almanya Bülteni) – Düsseldorf
Fotoğraf. (AA)